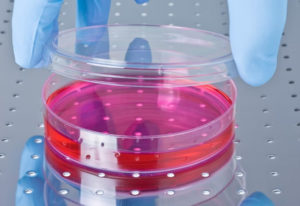

ヒト歯髄幹細胞を用いた再生医療
他の追随を許さない圧倒的なエクソソーム量
クリニック基準の安全性でエクソソーム量400pg/ml超えの高品質。Dr.歯髄幹細胞上清液について。

医師の学会が認めた歯髄幹細胞培養上清液

他の追随を許さない圧倒的なエクソソーム量
クリニック基準の安全性でエクソソーム量400pg/ml超えの高品質。Dr.歯髄幹細胞上清液について。
Dr.歯髄幹細胞上清液エクソソームによる各種治療を提供している加盟歯科医院
クリニック向け 高濃度エクソソーム提供プログラム

高品質・高濃度のエクソソームを用いて、お客様へ再生医療を提供。
第三期加盟医院追加募集中です。